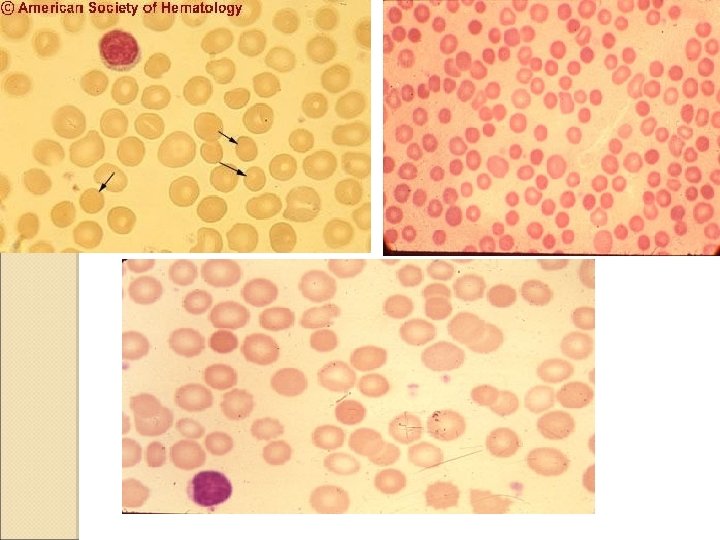
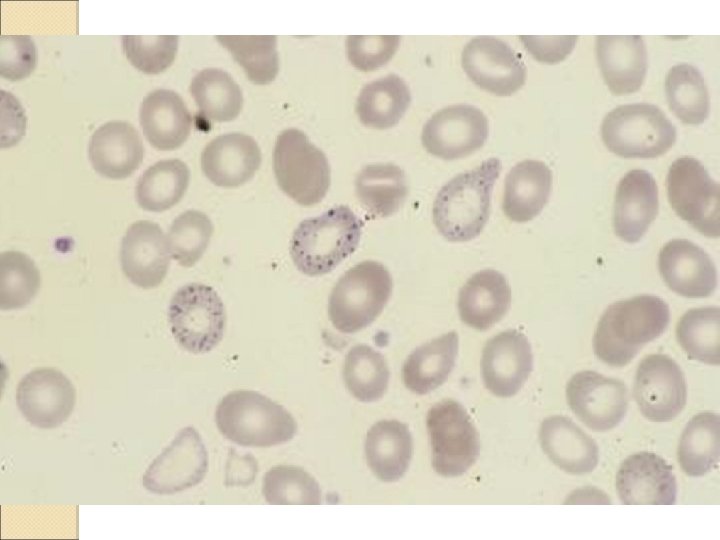

Hemolytic Anemias Prof Dr Reha Cengizlier 19 9

- Slides: 74
Hemolytic Anemias Prof. Dr. Reha Cengizlier 19. 9. 2014
Amaç: � Öğrencilerin hemolitik anemi nedenlerini bilmesi, hangi bebekte ne zaman anemi düşünüleceğini değerlendirebilmesi � Anemi düşünülen bebekte hangi tür anemi olabileceğini öğrenmesi, bunun için hangi tahlillerin yapılacağına karar verebilmesi ve bunun sonuçlarını yorumlayabilmesi � Tedavi ile komplikasyon ve mortaliteyi azaltabileceğini bilerek erken tanı ve tedavinin önemini kavraması
Hedefler ve tutum: � Hangi çocuğun anemik olduğunu ayırt edebilmeli � Bunun hangi tür anemi olduğunun ayırıcı tanısını yapabilmeli � Hangi yaşta hangi anemilerin belirti verebileceğini ayırt ederek uygun tetkikleri istemeli � Tahlil sonuçlarına göre aneminin mikrositer, makrositer, normositer olduğunu anlayabilmeli � Tetkik sonuçlarını yorumlayabilmeli � Tanıya yönelik tedavileri, kullanılacak yöntemleri bilmeli
Hedefler ve tutum: � Düşündüğü anemiye yönelik fizik muayene bulgularını ortaya çıkaracak muayeneyi yapabilmeli � Muayenede splenomegalinin önemini bilmeli � Anemilerin erken tanısının ve tedavisinin hayat kurtarmadaki ve sekelleri önlemedeki yerinin bilinci ile hastaya ve aileye yaklaşıp yönlendirmeli � Gerekiyorsa genetik danışmaya, veya kemik iliği nakline yönlendirmeli ve ikna etmeli
Congenital hemolytic anemias ◦ H. Elliptocytosis, H. pyropoikilocytosis ◦ H. stomatocytosis ◦ H. achantocytosis � Enzyme defects ◦ G 6 PD deficiency ◦ Pyruvate kinase (Embden-Meyerhof) ◦ P 5’N(nucleotid metabolism) ıntracorpuscular � Membrane defects ◦ Hereditary spherocytosis(HS) � Hemoglobin defects ◦ - thalassemia (quantitative hemoglobinopathies) ◦ Hb. S (qualitative hemoglobinopathies)
�Immune hemolytic anemia ◦ Isoimmune �Mismatched blood transfusion �Hemolytic disease of the newborn ◦ Autoimmune �Action of Ig �Idiopathic, secondary to number of conditions Coombs’ test (+)
�Non-immune hemolytic anemia ◦ Infections, drugs, underlying hematologic disease, microangiopathic HA, hypersplenism Coombs’ test (-)
Hereditary spherocytosis �Familial hemolytic disorder �Marked heterogenicity of clinical features ◦ Asymptomatic condition ◦ Fulminant hemolytic anemia �The morphologic hallmark of HS ◦ Microspherocyte ◦ Abnormal osmotic fragility
Hereditary spherocytosis. Clinical findings �Anemia �Jaundice �Splenomegaly Clinical features of HS
Hereditary spherocytosis. Clinical findings: �Anemia or hyperbilirubinemia (may require exchange transfusion in the neonatal period) �Anemia (mild to moderate) �Cholelithiasis may be the first sign of mild HS �Severity: ◦ Mild (20 -30%) ◦ Moderate (most common, 60 -75%) ◦ Severe (5%, requires RBC transfusions)
Hereditary spherocytosis �An intrinsic genetic defect causes defects in membrane proteins �The major complications ◦ Aplastic or megaloblastic crisis ◦ Hemolytic crisis ◦ Cholecystitis and cholelithiasis ◦ Severe neonatal hemolysis
Hereditary Spherocytosis. Pathophysiology ◦ Spectrin deficiency or disfunction* ◦ Ankyrin deficiency or disfunction ◦ Band 3 or, - Protein 4. 2 deficiency
Hereditary spherocytosis �HS usually is transmitted as an autosomal dominant trait �An autosomal recessive mode of inheritance also occurs 20 -25% of all HS cases
Hereditary spherocytosis. Laboratory findings �Minimal or no anemia �Reticulocytosis �Increased MCHC �Spherocytes on the peripheral ◦ Howell-Jolly bodies may be seen �Hyperbilirubinemia �Abnormal osmotic fragility blood smear test ◦ Hemolysis of HS cells may be complete at a solute concentration that causes little or no lysis of normal cells �LDH increased �Increased unconjugated bilirubin
Hereditary spherocytosis. Treatment � Neonates ◦ Phototherapy/exchange transfusion � Aplastic crisis ◦ RBC transfusion � Folic acid supplementation to prevent megaloblastic crisis � Splenectomy (after 6 years of age) ◦ Increased Hb level ◦ Decreased reticulocyte count ◦ Appereance of Howell-Jolly bodies and target cells ◦ Thrombocytosis
Hereditary Elliptocytosis Hereditary Stomatocytosis Clinical manifestations ◦ Autosomal dominant mode of inheritance ◦ Most patients are symptom free ◦ About 12% of patients have symptoms (anemia, splenomegaly, jaundice)
Glucose 6 phosphate dehydrogenase deficiency (G 6 PD) �X-linked disorder �Polymorphic with more than 300 reported variants �The highest prevalance rates are found in tropical Africa, the Middle East, some areas of Mediterranean (severe forms)
Glucose 6 phosphate dehydrogenase deficiency- Pathophysiology �G 6 PD enzyme catalyzes the oxidation of glucose-6 -phosphate to 6 phosphogluconate while reducing the (NADP+) to (NADPH)
Glucose 6 phosphate dehydrogenase deficiency- Pathophysiology �NADPH ◦ Protects the cells against oxidative stress ◦ Required cofactor in many biosynthetic reactions ◦ Maintains glutathion in its reduced form �Glutathion acts a scavanger for dangerous oxidative metabolites in the cell �Converts harmful hydrogen peroxide to water with the help of glutathion peroxidase
Glucose 6 phosphate dehydrogenase deficiency- Clinical findings � The most common clinical � Symptomatic patients feature is no symptoms ◦ Neonatal jaundice �Appears by age 1 -4 days �Often requires exchange transfusion ◦ Acute hemolytic anemia �Results from stress factors such as oxidative drugs or chemicals, infection or ingestion of fava beans ◦ Jaundice and splenomegaly may be present during crisis
Glucose 6 phosphate dehydrogenase deficiency- Laboratory findings �Anemia �Reticulocytosis �Activity of G 6 PD is low (after hemolysis) �Indirect hyperbilirubinemia �Decreased serum haptoglobin levels �Formation of “Heinz body” which consist of denaturated hemoglobin
Glucose 6 phosphate dehydrogenase deficiency- Treatment �Avoid oxidant drugs �Antimalarial drugs, nitrofurantoin, nalidixic acid, ciprofloxacin, methylene blue, chloramphenicol, phenazopyridine, vit K analogs, sulfonamides, acetanilid, doxorubicine, isobutyl nitratre, naphtalene, phenylhydrazine, pyridoxin �Exchange transfusion �RBC transfusion
Heinz bodies
Pyruvate Kinase Deficiency �Most common enzyme abnormality in the Embden -Meyerhof pathway �Autosomal resesive inheritance �Defective red cell glycolysis with reduced ATP Clinical features �Anemia, neonatal jaundice, splenomegaly �Gallstones, hemosiderosis from multiple tx �Aplastic crisis �Bone changes of chronic hemolytic anemia
Laboratory findings Features are; Macrocytes, polychromasia, anisocytosis, spherocytes, contracted red cells (acanthocytes, pyknocytes) �Erythrocyte PK activity is decreased to %5 - 20 �Erythrocyte 2, 3 DPG is increased �Autohemolysis is markedly increased
Treatment �Folic acid supplemantation �Transfusion as required �Splenectomy does not arrest hemolysis, but does decrease transfusion requirements
Pirimidine 5’ Nucleotidase Deficiency � Autosomal resesive inheritance � Chronic hemolytic anemia � Newborn Jaundice � Gall stones Laboratory findings � Anemia, reticulocytosis, indirect bilirubinemia � Basophilic stippling � P 5’N enzyme activity Treatment � Folic acid, transfusion, splenectomy (Partial correction)
Thalassemia (Cooley’s anemia, Mediterranean Anemia) � An inability to manufacture sufficient quantities of globin chains � In the adult there are 3 Hb types normally present ◦ Hb A 2 2 (95% of total) ◦ Hb A 2 2 2 (3% of total) ◦ Hb. F 2 2 (2% of total) (During fetal life the majority of Hb) � During embryonic life at least 2 different Hbs are produced ◦ Gowers 2 (2 2 chains) ◦ Gowers 1 (4 chains) ◦ The manufacture of each of these chains is controlled by spesific genes
Thalassemia �There is a genetic failure in the production of globin chains �Failure of production of and chains is the most common ◦ thalassemia �a failure of beta chain production ◦ thalassemia �a failure of alpha chain production
Beta Thalassemia �The genes controlling beta chain are located on chromosome 11 � thalassemia major ◦ If both genes fail � thalassemia minor ◦ If only one gene fails
Beta Thalassemia minor (Heterozygous) (B+) �Most common of thalassemias �Beta chain production is less than normal �Alpha chain production continues at a near normal rate �Decreased level of Hb. A �Excess alpha chains stimulates the increased production of delta chains ◦ Increased amount of Hb. A 2 �Rate of gamma chain production is greater ◦ Increased amount of Hb. F
Beta Thalassemia minor �These patients are not severely anemic �These patients can be provided appropriate genetic counselling �Hb, Hct are decreased �RBC count is not as low as the Hb and Hct ◦ Bone marrow produce the cells but cannot fill them with Hb �RBCs are microcytic and hypochromic �Normal RDW
Beta Thalassemia minor �MCV is slightly decreased �MCH is decreased �MCHC is normal �WBC count is normal �Reticulocyte count is relatively increased �Bone marrow is either normal or undergoes slight erythroid hyperplasia �Serum iron, ferritin is normal �Bilirubin slightly increase due to intramedullary hemolysis
Beta Thalassemia minor �Hb studies ◦ Hb. A decreased ◦ Hb. A 2 increased ◦ Hb. F normal to slightly increased
Beta Thalassemia major (homozygous)(B 0) �Complete failure of beta chain production �Raised levels of Hb. A 2 and Hb. F ◦ Hb. F has a very high affinity for oxygen (poor oxygen deliverer) �Only functional Hb is Hb. A 2 ◦ The patient is hypoxic �Increased erythropoietin production �Stimulates the marrow to maximum �Typical facial appereance �Splenomegaly ◦ Extramedullary hemopoiesis
Beta Thalassemia major �Patients develop a life threatening anemia by one or two months (mostly often 6 months) �Severe anemia (Hb: 2 -3 mg/dl) ◦ Hct and RBC count are also decreased �MCV, MCHC are all decreased �Hypochromic microcytic RBC ◦ Anisocytosis, poikilocytosis, target cells �Reticulocytosis �WBC is increased at the beginning
Beta Thalassemia major �Bone marrow undergoes erythroid hyperplasia �Serum Fe increased/normal �Ferritin increased/normal �Hb electrophoresis ◦ Hb. A decreased ◦ Hb. A 2 variable ◦ Hb. F increased
Beta Thalassemia major �The patients must be supported with blood transfusions which result in iron overload �Unless iron is removed with appropriate chelation therapy these patients die of hemosiderosis �Splenectomy ◦ When the yearly transfusion requirement of packed red cells exceeds 200 -250 ml/kg �Bone marrow transplantation
Thalassemia minor=Thalassemia trait
Thalassemia major
Alpha thalassemia �Four genes coding for alpha chain production �These genes are located on chromosome 6 �There at least five forms of alpha thalassemia depending on the number and location of abnormal genes
Hydrops fetalis- Homozygous alpha thalassemia �All genes are abnormal �There is no alpha chain production ◦ No Hb. F production and death in utero �At autopsy the cord blood shows severe anemia �There is no Hb. A and Hb. F on electrophoresis ◦ most of the Hb is Hb. Bart’s which consists of 4 gamma chains
Hemoglobin H disease �Three genes are abnormal and one gene is coding for alpha chains �Limited production of Hb. F in utero and Hb. A after birth �Infant is anemic at birth �RBC and hct count are also decreased
Heterozygous alpha thalassemia (minor) �Depends on whether or not the two deleted genes are on the same chromosome �In alpha th O, both genes are absent from the same chromosome �In alpha th +, one gene is missing from each chromosome �In both forms ◦ Minor changes ◦ Mild anemia ◦ MCV and MCHC are borderline low
Alpha thalassemia silent �Only one of the four genes is abnormal �There is a near normal production of alpha chains with very few if any clinical or laboratory changes
Beta thalassemia variants �Delta/beta �Hb. Lepore th
Sickle cell anemia �Qualitative hemoglobinopathy �Valine is substituted instead of glutamine in the sixth position on the globin molecule �Sickle cell anemia is caused by homozygosity for the sickle cell gene and is the most common form of sickle cell disease �The charge at this site is altered and allows for polymerization of Hb under conditions of hypoxia
Sickle cell anemia �Polymerization of sickle Hb ◦ distorts erythrocyte morphology ◦ causing a marked reduction in RBC life span ◦ increases blood viscosity ◦ predisposes to episodes of vasoocclusion
Sickle cell anemiaclinical findings �Children are normal at birth ◦ Onset of sx. is usually after 3 -4 months of age ◦ High levels of Hb. F inhibits sickling �Moderately severe hemolytic anemia is often present by age 1 year �Pallor, fatigue, jaundice �Predispozition to the development of gallstones
Sickle cell anemiaclinical findings � Intense congestion of the spleen with sickled cells may cause ◦ splenomegaly in early childhood ◦ functional asplenia as early as age 3 months �Great risk for infection with encapsulated bacteria � Acute splenic sequesteration ◦ sudden enlargement of spleen with pooling of red cells; Acute exacerbation of anemia, shock, death � Aplastic crisis ◦ Caused by infection with human parvovirus
Sickle cell anemia-clinical findings �Vasoocclusive crisis ◦ Hand-foot syndrome ◦ Abdominal pain ◦ Musculoskeletal pain ◦ Stroke ◦ Acute chest syndrome �Fever, pleuritic chest pain, acute pulmonary infiltrates
Sickle cell anemia-laboratory findings �Decreased Hb (7 -10 g/dl) with normal MCV �Reticulocytosis �Characteristic sickle cells �Hb electrophoresis ◦ Hb. S
Sickle cell anemia-treatment �Patient and family education �Prevention of complications and optimization of health �All children should be immunized with the conjugate pneumococcal vaccine �At the age of 2 months all children should begin penicillin prophylaxis (At least up to 5 years of age)
Sickle cell anemia-treatment � Treatment of painful vaso-occlusive episodes ◦ Adequate hydration ◦ Correction of acidosis if present ◦ Administration of analgesics ◦ Maintenance of normal oxygen saturation ◦ Treatment of associated infection � RBC transfusion ◦ In acute exacerbation � Exchange transfusion � Hydroxyurea � Bone marrow transplantation
Sickle cell trait �Individuals who are heterozygous for the sickle gene �Hb electrophoresis ◦ Hb. A 60% ◦ Hb. S 40% ◦ Normal levels of A 2 and F �No anemia, no hemolysis
Sickle cell trait �Exposure to environmental hypoxia may precipitate splenic infarction or sequestration �Sudden death during exercise? �Hematuria �Bacteriuria �Intraocular bleeding �Genetic counselling is important
Hb. E �Hemoglobinopathy (not a thalassemia) �Production �Beta of abnormal globin chains chain variant in which lysine is substituted for glutamic acid in position 26 �Mild anemia �Reticulocyte count slightly increased �Serum iron, ferritin increased/normal
Autoimmune Hemolytic Anemias �Hemolytic disease of the newborn �Various infections (Epstein-Barr virus, rarely HIV, cytomegalovirus, and mycoplasma), �Immunologic diseases (systemic lupus erythematosus [SLE], rheumatoid arthritis) �Immunodeficiency diseases (agammaglobulinemia, autoimmune lymphoproliferative disorder, dysgammaglobulinemias)
Autoimmune Hemolytic Anemias �Neoplasms (lymphoma, leukemia, and Hodgkin disease) �Drugs (methyldopa, l-dopa) �Other drugs (penicillins, cephalosporins) cause hemolysis by means of “drugdependent antibodies—that is antibodies directed toward the drug and in some cases toward an RBC membrane antigen as well
Hemolytic disease of the newborn �Rh antigen �Maternal antibody production �Ig. G crosses placenta into the fetal circulation �Reacts with the Rh Ag on fetal erythrocytes �These antibody coated cells are recognized as abnormal and are destroyed by the spleen �Production of bilirubin
Hemolytic disease of the newborn �Mild hemolysis �Severe anemia, erythroblastosis fetalis �Cardiac decompensation, massive anasarca, circulatory collapse �Hydrops fetalis (abnormal fluid in two or more fetal compartments) �The use of anti-D gammaglobulin (rho. Gam) including antenatal administration at 26 -28 weeks’ gestation
ABO incompatibility �ABO incompatibility is limited to mothers of blood group O and affects infants of blood group A or B �All group O individuals have naturally occurring anti-A and anti-B antibodies, previous sensitization is not necessary �Clinical disease is milder